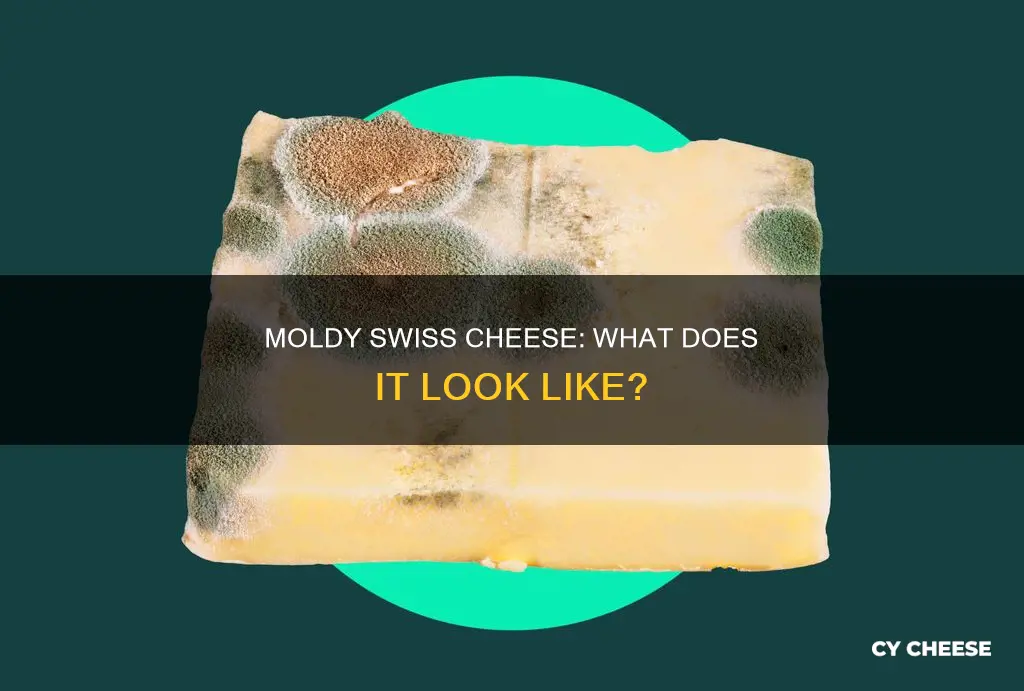
what does mold on swiss cheese look like

It's a common dilemma: you go to grab some cheese from the fridge and find that it's sporting a fuzzy, polka-dot coat of mould. But is it safe to cut off the mouldy part and eat the rest? The answer depends on the type of cheese and the type of mould. Harder, aged cheeses like Swiss cheese can usually be salvaged if mould growth is caught early, but soft cheeses like ricotta or cottage cheese should be discarded if mouldy.
| Characteristics | Values |
|---|---|
| Appearance | Blue spots, discolouration, or any growth that wasn't there when purchased |
| Texture | Fuzzy |
| Type of cheese | Hard cheeses |
| Type of mold | White, blue, or green fuzz |
| Impact on cheese | May affect the flavour of the cheese |
| Edibility | Can be consumed after cutting off the moldy spots, but only if it is a hard cheese |
Explore related products
What You'll Learn

Hard cheeses can be salvaged if mouldy
The safety of eating mouldy cheese depends on several factors, including the type of cheese and the extent of mould growth. While mouldy cheese, like all other mouldy foods, should be thrown away, hard cheeses like Swiss, Parmesan, Cheddar, and Colby can be salvaged by cutting away the mouldy area. This is because the mould's mycelium cannot penetrate very deep into the cheese, and toxins produced by the mould do not spread beyond the surface due to the lack of moisture. However, it is important to cut at least 1 inch (2.5 cm) around and below the mouldy spot to ensure all contamination is removed.
Soft cheeses, such as cottage cheese, cream cheese, ricotta, mascarpone, goat cheese, feta, and mozzarella, should be discarded if any mould is present. These cheeses have a higher moisture content, which allows mould to penetrate more deeply and potentially spread harmful bacteria, such as Listeria, Salmonella, and E. coli. These pathogens can multiply rapidly, even at refrigeration temperatures, and can cause serious illness in some individuals.
It is also important to note that some moulds can cause allergic reactions, respiratory problems, or, in rare cases, produce toxins that can make you sick. Therefore, if you are unsure, it is best to err on the side of caution and throw the cheese away.
Mould is a type of fungus that produces spores, and it is these spores that can cause food to spoil. While mould is generally a sign of spoilage when it grows on food, some types of mould are used to produce certain cheeses, such as blue cheese, Brie, and Camembert. These cheeses are made using specific mould cultures that are safe to consume.
The Unique Taste of Greensward Cheese Explained
You may want to see also

Soft cheeses should be discarded if mouldy
While mould is a natural part of the cheese-making process, soft cheeses should be discarded if they become mouldy. Soft cheeses, such as mozzarella, burrata, ricotta, mascarpone, paneer, feta, and similar varieties, are highly perishable and should be consumed shortly after they are made. If these types of cheese develop mould, it is best to throw them away.
It is important to note that not all moulds are harmful. In fact, mould plays a crucial role in the flavour and texture of many types of cheese. However, when it comes to soft cheeses, it is generally safer to discard them if they become mouldy. This is because soft cheeses have a higher moisture content, which can provide a more favourable environment for the growth of certain harmful moulds.
While some harder cheeses, such as cheddar, can be salvaged by cutting off the mouldy portion, this is not recommended for soft cheeses. The mould on soft cheeses can quickly spread throughout the cheese, increasing the risk of consuming harmful bacteria or toxins. Additionally, soft cheeses are more susceptible to spoilage, and the presence of mould indicates that the cheese has likely passed its prime and is no longer safe to eat.
It is always better to err on the side of caution when it comes to food safety. If you are unsure whether a soft cheese is safe to eat due to mould, it is best to discard it. Preventing foodborne illnesses and protecting your health are far more important than salvaging a small amount of cheese. By promptly discarding mouldy soft cheeses, you can help ensure that you maintain safe and healthy eating habits.
Goat Cheese Sauce: A Tangy, Creamy Delight
You may want to see also

Blue or green fuzz on Swiss cheese is bad
Swiss cheese is a hard cheese, and so if it has mold on it, the affected area can be cut off and the rest of the cheese can be eaten. However, blue or green fuzz on Swiss cheese is bad and should not be consumed. This is because blue or green fuzz indicates the presence of unintentional mold, which can be harmful.
While it is true that mold plays a crucial role in the cheesemaking process, not all molds are safe for consumption. In fact, some molds can cause allergic reactions, respiratory problems, or, in rare cases, produce toxins that can make you ill. Therefore, it is important to be able to distinguish between the "good" and "bad" mold on cheese.
Unintentional mold on Swiss cheese, which can appear as blue or green fuzz, should be discarded. This type of mold can indicate the presence of harmful bacteria and toxins that can be dangerous for consumption. It is always better to be cautious and discard the moldy cheese rather than risk potential health issues.
On the other hand, Swiss cheese that has been intentionally molded during the cheesemaking process can be safely consumed. This type of mold is usually white and may be tinged with blue or green veins, which are characteristic of certain varieties of Swiss cheese. However, if the mold appears to be excessive or unusually colored, it is best to discard the cheese.
To prevent mold from growing on Swiss cheese, it is important to store it properly and consume it within a reasonable timeframe. Additionally, purchasing long-aged, hard cheeses like Parmesan or aged Cheddar can help reduce the likelihood of encountering mold issues.
Jack Cheese: A Mild, Buttery Taste Experience
You may want to see also
Explore related products

White, fuzzy mould on Swiss cheese is fine
It is generally safe to consume white, fuzzy mould on Swiss cheese. This mould is usually Penicillium candidum, which is the same kind that appears on Brie and Camembert cheeses. It is also known as "bloomy rind" and is considered safe for consumption. In fact, it is recommended that you eat the rind on these types of cheeses as it can add flavour and texture to your dish.
However, it is important to note that while most mould on cheese is harmless, there are some rare types of mould that can be dangerous. For example, the dark black-grey mould Aspergillus niger can be harmful. If you are unsure about the type of mould on your cheese, it is always best to err on the side of caution and discard it.
Additionally, while white, fuzzy mould on Swiss cheese is typically safe, it may not always be aesthetically pleasing or taste appealing. If the mould has a bitter flavour or an unappetising texture, it is recommended to cut off the affected parts of the cheese. As mould grows, it can develop roots that penetrate the cheese, so be sure to cut generously around the mouldy area to ensure all roots are removed.
To prevent mould from growing on your Swiss cheese, proper storage is essential. Store your cheese in a clean, sanitised container or wrap it tightly in plastic wrap or cheese paper. Keep it in the refrigerator, where the cool temperature will help to slow down the growth of any mould spores. Additionally, regular inspection of your cheese will help you catch any signs of mould early on, allowing you to enjoy your Swiss cheese without worry.
In conclusion, white, fuzzy mould on Swiss cheese is generally safe to consume and can even be considered a delicacy by some. However, always use your best judgement and, if in doubt, discard the cheese. By following proper storage practices and regularly checking your cheese for mould, you can minimise the risk of harmful mould growth and safely enjoy your Swiss cheese.
Vaginal Odor: Why Does It Smell Like Cheese?
You may want to see also

Black or grey mould on Swiss cheese is bad
Swiss cheese is a hard cheese, and as such, it can be salvaged if mould growth is spotted. However, black or grey mould on Swiss cheese is bad and should be discarded. Harder, aged cheeses like aged Cheddar or Parmesan can have mould safely scraped away, but this only applies to white, fuzzy mould with a tinge of green. Black or grey mould is less desirable, and more of the cheese around it should be cut away to ensure that none of the parts impacted by the mould remain.
While it is rare for mould to grow on cheese and present a health concern, black-grey mould, or Aspergillus niger, is one of the few types of mould that is unsafe for consumption. It is important to note that moulds can cause allergic reactions, respiratory problems, or, in rare cases, produce toxins that can make you sick. Therefore, it is always best to err on the side of caution and throw away any cheese with black or grey mould.
The presence of mould on Swiss cheese can be prevented by storing the cheese properly and consuming it within a reasonable timeframe. Swiss cheese is known for its holes, which are caused by bacteria that produce carbon dioxide and gas during the cheese-making process. These holes provide an ideal environment for mould to grow, so it is essential to take preventive measures to avoid mould growth.
While it may be tempting to cut away the mouldy parts of Swiss cheese and consume the rest, it is important to prioritize food safety. Black or grey mould on Swiss cheese indicates that the cheese is no longer safe to eat, and proper disposal is necessary to prevent potential health risks.
In summary, black or grey mould on Swiss cheese is bad and should not be consumed. It is important to practice safe food handling and avoid the potential risks associated with mould contamination.
The Taste of Granola Cheese: A Unique Experience
You may want to see also
Frequently asked questions
Mold on Swiss cheese can appear as blue spots or discoloration on the uniformly colored cheese.
It is not recommended to eat moldy Swiss cheese. While some suggest that the moldy parts can be cut off, it is best to err on the side of caution and discard the entire block.
Swiss cheese is a hard cheese, and hard cheeses are more susceptible to mold growth due to their lower moisture content.
To prevent mold growth on Swiss cheese, it is important to store it properly and consume it within a reasonable timeframe.
No, there are no known benefits to consuming moldy Swiss cheese. While some molds used in cheesemaking can add flavor and texture, unintentional mold growth on Swiss cheese can negatively impact its flavor and may even be harmful.

























